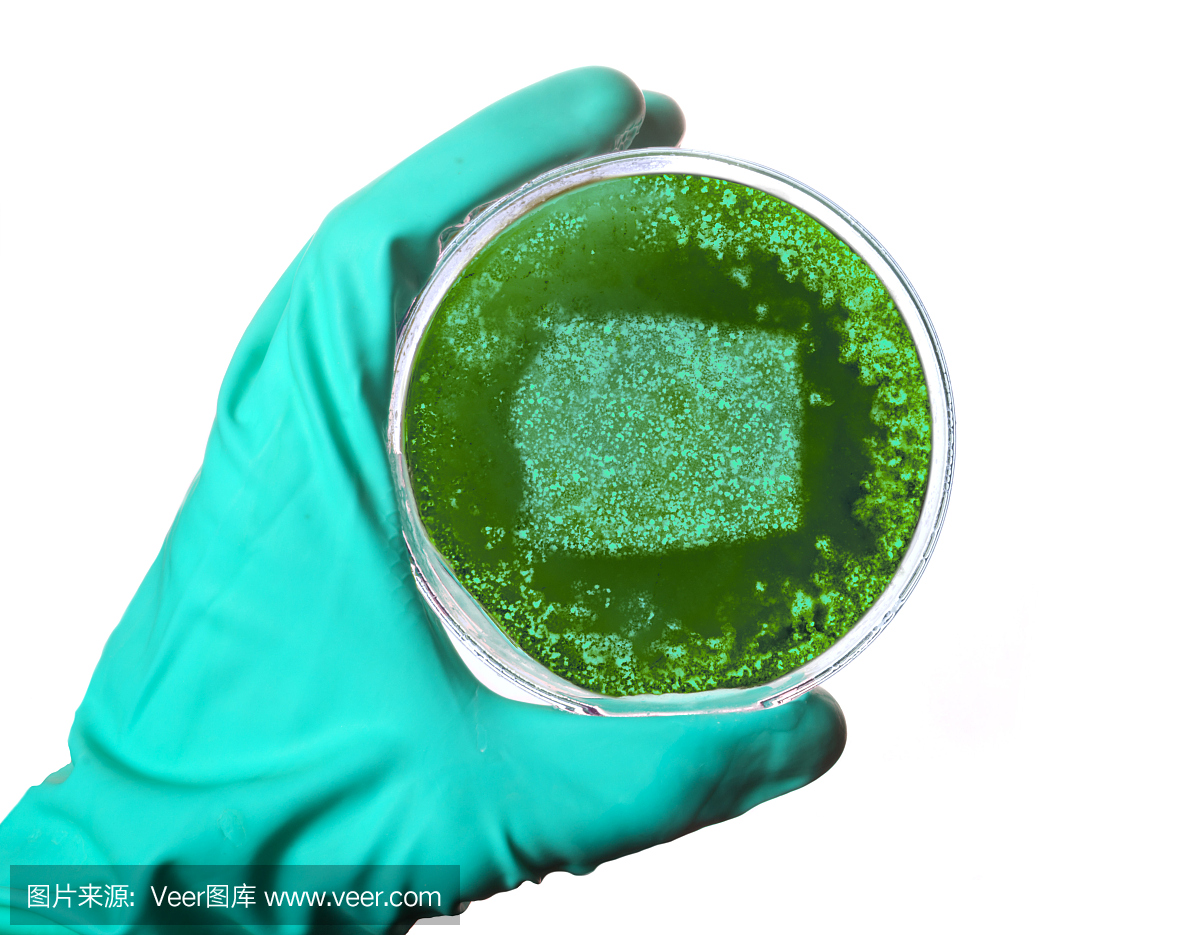
赤道几内亚,赤道基内亚,皮氏培养皿,琼脂

道基_道基服饰_dokie - krystal
750x451 - 64KB - JPEG

道基-Android安卓市场,电子市场,国内最专业的
320x480 - 29KB - JPEG

道基村与三十六塘-永嘉,三十六,山塘,道基,仙
400x267 - 224KB - JPEG

赤道几内亚,赤道基内亚,水果,无人
1200x1200 - 1439KB - JPEG

赤道几内亚,赤道基内亚,英文字母T,T字母的
1200x1200 - 354KB - JPEG

赤道几内亚,赤道基内亚,几内亚,基里亚
1200x975 - 686KB - JPEG

赤道几内亚,赤道基内亚,自然,水平画幅
1200x970 - 1186KB - JPEG

赤道几内亚,赤道基内亚,几内亚,基里亚
1200x988 - 696KB - JPEG

赤道几内亚,赤道基内亚,几内亚,几尼亚
1200x958 - 856KB - JPEG
赤道几内亚,赤道基内亚,皮氏培养皿,琼脂
1200x935 - 559KB - JPEG

赤道几内亚,赤道基内亚,火山,火山作用
1200x899 - 964KB - JPEG

赤道几内亚,赤道基内亚,几内亚,几尼亚
1200x886 - 636KB - JPEG

赤道几内亚,赤道基内亚,黑沙,黑沙滩
1200x899 - 1306KB - JPEG

赤道几内亚,赤道基内亚,黑沙,黑沙滩
1200x899 - 1290KB - JPEG

赤道几内亚,赤道基内亚,摄影,教堂
1200x1200 - 1436KB - JPEG
DOKIE道基:DOKIE诞生于广州,所属广州道基服饰有限公司,成立伊始便以引导时尚潮流为己任。致力于通过DOKIE男装品牌的运营和网络销售渠道的拓展,将最新的时尚服饰带
再看别的新书又没心思看进去,出现书荒也是非常难受的。下面小编就为大家带来几部精彩小说!少年穿梭诸天万界,灵士巩固道基,巫师得窥真理,神话
简介:治理之道的根本。《文选·张协之三》"高尚遗王侯,道积自成基" 李善 注引《庄子》:"无为无治,谓之道基。" 晋
本站提供小说玄幻时代:提前登陆最新章节:第十八章古萱儿的震惊,跨入道基一重!【一更,求鲜花评价票】免费在线阅读,在线连载及下载,希望本站能给您的阅读带来安静与喜悦!
第二九二章撼动道基炼紫气,欲与小魔佛合作 一品修仙不放心油条8279字 2018.07.25 23:14 秦阳颤抖的伸出手,一脸苦恼,仰天长叹。 “妈耶,这么多,我要花费多少时间,才能将
李道基,开始更新在东京的留学记录,愿你能住进我的眼睛。微博@李道基,bilibili是国内知名的视频弹幕网站,这里有最及时的动漫新番,最棒的ACG氛围,最有创意的Up主。大家可
机场道基道面工程 任课教师:童朝霞 工训中心东 413-3 房间 15810989142 tongzx@buaa.edu.cn 参考书目 1. 翁兴中,蔡良才.机场道面设计.人民交通出版社. 2007. 2. 黄晓明,朱湘